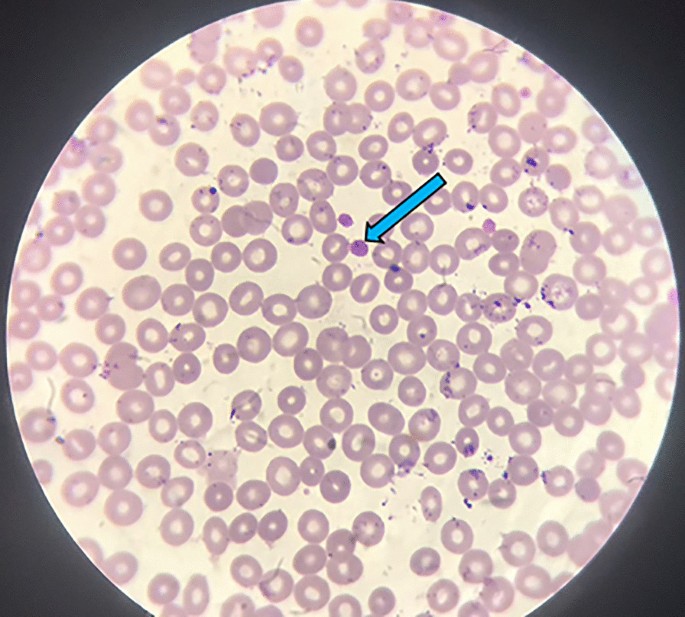
figure 1

- Case Report
- Open access
- Published:
Partial splenic artery embolization (PSE) in a patient with grey platelet syndrome (GPS): a case report
Egyptian Journal of Radiology and Nuclear Medicine volume 53, Article number: 80 (2022)
Abstract
Background
Grey platelet syndrome (GPS) is a rare cause of mild-to-severe bleeding. Up till now, there has been no definite treatment for GPS.
Case presentation
We reported a case diagnosed as GPS and presented with menorrhagia, metrorrhagia, gingival bleeding, and left hypochondrial pain. The platelet count was 18 thousand/cmm. Ultrasound splenic diameter was 22.0 cm. The multidisciplinary team decided to perform splenectomy; however, the patient was unfit for surgery. Partial splenic artery embolization (PSE) was performed. Follow-up after 24 months showed a normal menstrual cycle and absent pain. Platelet count rise to 70, 55, and 51 thousand/cmm after 1, 12, and 24 months, respectively. Splenic diameter showed a significant decrease to 11.2 cm after 24 months.
Conclusion
PSE is effective and safe in symptomatic patients with GPS.
Background
Grey platelet syndrome (GPS) is a rare inherited platelet disorder characterized by loss of the α-granules storage pool of proteins in platelets and causing bleeding tendency [1]. Long-term follow-up revealed the progressive nature of thrombocytopenia and myelofibrosis, resulting in fatal haemorrhages in several patients [2].
Most cases are detected in childhood or early adolescence by a history of bleeding tendency. For diagnosing GPS, haematological and biochemical tests, platelet lysate analysis, platelet aggregation tests, and flow cytometry can be valuable. However, the gold standard is transmission electron microscopy, which can confirm the absence of platelet α-granules [3, 4]. Reports on GPS are confined to case studies. To date, 100 published cases have been recorded worldwide [3,4,5,6].
Up till now, there is no particular treatment for GPS, and the appropriate therapy is on-demand management and medical support. Splenectomy was used as an option to increase the platelets count and decrease the risk of bleeding [1]. Partial splenic artery embolization (PSE) is an accepted alternative for splenectomy, especially in patients unfit for surgery [7]. We herein report a case of GPS treated by PSE.
Case presentation
A 24-year-old female presented with a history of mild bruises and petechiae. No history of trauma. She was born with mitral valve stenosis. When she was 21, she complained of heavy menstrual bleeding, intermenstrual bleeding, gingival bleeding, shortness of breath, and severe pain in the left hypochondrium. No family history of bleeding or drug use. Chest X-ray was normal. Abdominal ultrasound (US) revealed marked hepatosplenomegaly (HSM). Complete blood picture (CBC) showed: TLC = 3.6 thousands/cmm, RBCs = 3.23 millions/cmm, Hb = 9.9 g/dl and platelet count = 41 thousands/cmm. Blood smear demonstrated giant agranular platelets (Fig. 1). Bleeding time was prolonged. Reticulocytic count = 4.8%. Erythrocyte sedimentation rate (ESR) = 5 mm/h. Bone marrow aspiration revealed no abnormalities except for a decrease in the free platelets, which were mainly large and agranular. Bone marrow biopsy revealed hypercellular bone marrow, active haematopoiesis, and associated fibrosis. No infiltration. Platelet function tests showed decreased aggregation by collagen, thrombin, and adenosine diphosphate (ADP). The diagnosis was GPS, and then the patient was discharged after receiving a blood transfusion.
Nine months later, the patient returned with the same presentations. US was done to detect the cause of the abdominal pain and showed only HSM (splenic diameter = 22.0). Contrast-enhanced computed tomography (CECT) was done and showed the same findings as in the US. CBC showed: TLC = 2.1 thousands/cmm, RBCs = 2.9 million/cmm, haemoglobin (Hb) = 9.5 g/dl, and platelet count = 18 thousands/cmm. Again, she received a blood transfusion and strong analgesics and was then discharged. The multidisciplinary team decided to do splenectomy since the enlarged spleen was supposed to be the aetiology of the left hypochondrial pain and to increase the platelet count and decrease the bleeding tendency. Unfortunately, the patient was unfit for surgery due to mitral valve stenosis and high bleeding tendency. The other option was to do PSE.
Antibiotic prophylaxis (1 gm of third-generation cephalosporin twice a day and metronidazole 500 mg/100 ml intravenous infusions daily) was started three days before procedure and maintained for seven days after. Then, for a further week, oral dose of Ciprofloxacin 500 mg/Metronidazole 500 mg twice daily. The patient was given pneumococcal, haemophilus influenza, and meningococcal vaccines. The morning of the procedure, the patient received four units of platelets. The femoral puncture was performed under local anaesthesia using a 6-F introducer sheath. The celiac trunk and splenic artery were catheterized with a 5-F Cobra catheter (Imager-Boston Scientific, Natick, Massachusetts) over a 0.035-inch hydrophilic guidewire (Terumo, Tokyo, Japan), then a microcatheter (Renegade HI-FLO microcatheter, Boston Scientific) was placed distal to the pancreatic branches (Fig. 2). Embolization was done using Embospheres microspheres 700–900 µ (Biosphere Medical, Rockland, MA) mixed with gentamicin 80 mg to diminish the incidence of splenic abscess and undiluted contrast. The fluoroscopic time was 8 min.
The patient was hospitalized for three days for observation, prophylactic antibiotic therapy, and pain management. The short-term clinical outcome was good; the patient suffered from pain controlled by analgesics. After 24 months of follow-up, the patient had a normal menstrual history, no left hypochondrial pain, and no gingival bleeding. Laboratory outcomes revealed a rise in the platelet count to 70, 55, and 51 thousand/cmm after 1, 12, and 24 months, respectively. The TLC changed to 7.9, 8.2, and 9.0 thousand/cmm after 1, 12, and 24 months, respectively. Regarding the radiological outcome, the CECT was done 30 days after the embolization. The whole spleen and the viable residual spleen were volumetrically measured in the venous phase and revealed that 61.65% of the spleen was infarcted (Fig. 3). The US was done before the discharge of the patient and revealed no complications. After 12 months, a follow-up US revealed a significant reduction in the splenic diameter (11.6 cm), which has remained relatively stable for two years (11.2 cm).
a Coronal reformatted CECT image at the arterial phase shows large non-enhancing areas throughout the spleen representing infarctions. b 3D coronal CT angiography image for the aorta and splenic artery shows the infarction of less density than viable tissue. c The volumetric analysis of the splenic volume is 925.026 cc. d The volumetric analysis of the viable tissue is 354.695 cc
Discussion
Since it was first described in 1973 by Maddison to treat bleeding oesophageal varices with hypersplenism, splenic artery embolization has been utilized in various clinical settings [8]. In the current case, we used the PSE in the treatment of GPS. To the best of our knowledge, this is the first case described in the literature in which the PSE was used for the treatment of GPS instead of splenectomy. The results were promising.
Our patient presented with bleeding tendency and severe left hypochondrial pain with a platelets count of 18 thousand/cmm. We aimed to control the bleeding and the left hypochondrial pain. In concordance with previous studies [9, 10], PSE using permanent embolizing material (Embospheres Microspheres) showed a significant increase in leucocytic and platelet counts at two-year follow-up. Heavy menstrual bleeding, intermenstrual bleeding, and gingival bleeding have all been stopped. The 50% reduction in the splenic volume was noted after 24 months, which could explain the disappearance of the left hypochondrial pain and match the results of other studies [10].
Conclusion
In GPS patients with bleeding, PSE could be an acceptable option for correcting thrombocytopenia and controlling the symptoms.
Availability of data and materials
N/A.
Abbreviations
- GPS:
-
Grey platelet syndrome
- PSE:
-
Partial splenic artery embolization
- US:
-
Ultrasound
- HSM:
-
Hepatosplenomegaly
- CBC:
-
Complete blood picture
- ESR:
-
Erythrocyte sedimentation rate
- ADP:
-
Adenosine diphosphate
- CECT:
-
Contrast-enhanced computed tomography
- Hb:
-
Haemoglobin
References
Nurden AT, Nurden P (2007) The gray platelet syndrome: clinical spectrum of the disease. Blood Rev 21:21–36
Gunay-Aygun M, Zivony-Elboum Y, Gumruk F et al (2010) Gray platelet syndrome: natural history of a large patient cohort and locus assignment to chromosome 3p. Blood 116:4990–5001
Perez Botero J, Im R, Chen D, Patnaik MM (2016) Grey platelet syndrome misdiagnosed as ITP. Br J Haematol 173:662
Albers CA, Cvejic A, Favier R et al (2011) Exome sequencing identifies NBEAL2 as the causative gene for gray platelet syndrome. Nat Genet 43:735–737
Laskey AL, Tobias JD (2000) Anesthetic implications of the grey platelet syndrome. Can J Anaesth 47:1224–1229
Fabbro S, Kahr WH, Hinckley J et al (2011) Homozygosity mapping with SNP arrays confirms 3p21 as a recessive locus for gray platelet syndrome and narrows the interval significantly. Blood 117:3430–3434
Nurden AT, Nurden P (2001) Inherited defects of platelet function. Rev Clin Exp Hematol 5:314–334
Dissanayake LK, Hewavithana PB, Rathnayake RM, Pethiyagoda AU (2018) Partial splenic artery embolization: an alternative management strategy for resistant thrombocytopenia of immune thrombocytopenic purpura (ITP). Sri Lanka J Med. 27(1):66
Zhu K, Meng X, Li Z et al (2008) Partial splenic embolization using polyvinyl alcohol particles for hypersplenism in cirrhosis: a prospective randomized study. Eur J Radiol 66:100–106
Zaitoun MMA, Basha MAA, Elsayed SB et al (2021) Comparison of three embolic materials at partial splenic artery embolization for hypersplenism: clinical, laboratory, and radiological outcomes. Insights Imaging 12(1):85
Acknowledgements
All staff members of the interventional radiology unit, Zagazig University Hospitals, Egypt.
Funding
No funding was obtained for this study.
Author information
Authors and Affiliations
Contributions
MZ and MB conceived of the presented idea. MZ, MB developed the theory and performed the computations. SS and NZ verified the analytical methods. RA investigated the case by laboratory investigations and supervised the findings of this work. MZ and MB did the procedure. All authors were major contributor in writing the manuscript. All authors discussed the results and contributed to the final manuscript. All authors read and approved the final manuscript.
Corresponding author
Ethics declarations
Ethics approval and consent to participate
Institutional review board’s approval was obtained. All procedures performed were in accordance with the ethical standards of the institutional and/or national research committee and with the 1964 Helsinki declaration and its later amendments. Written informed consent was obtained from the patient.
Consent for publication
Written informed consent to publish this information was obtained from the patient.
Competing interests
The authors declare that they have no competing interests.
Additional information
Publisher's Note
Springer Nature remains neutral with regard to jurisdictional claims in published maps and institutional affiliations.
Rights and permissions
Open Access This article is licensed under a Creative Commons Attribution 4.0 International License, which permits use, sharing, adaptation, distribution and reproduction in any medium or format, as long as you give appropriate credit to the original author(s) and the source, provide a link to the Creative Commons licence, and indicate if changes were made. The images or other third party material in this article are included in the article's Creative Commons licence, unless indicated otherwise in a credit line to the material. If material is not included in the article's Creative Commons licence and your intended use is not permitted by statutory regulation or exceeds the permitted use, you will need to obtain permission directly from the copyright holder. To view a copy of this licence, visit http://creativecommons.org/licenses/by/4.0/.
About this article
Cite this article
Zaitoun, M.M.A., Abdullah, R.M., Zaitoun, N.A. et al. Partial splenic artery embolization (PSE) in a patient with grey platelet syndrome (GPS): a case report. Egypt J Radiol Nucl Med 53, 80 (2022). https://doi.org/10.1186/s43055-022-00760-w
Received:
Accepted:
Published:
DOI: https://doi.org/10.1186/s43055-022-00760-w